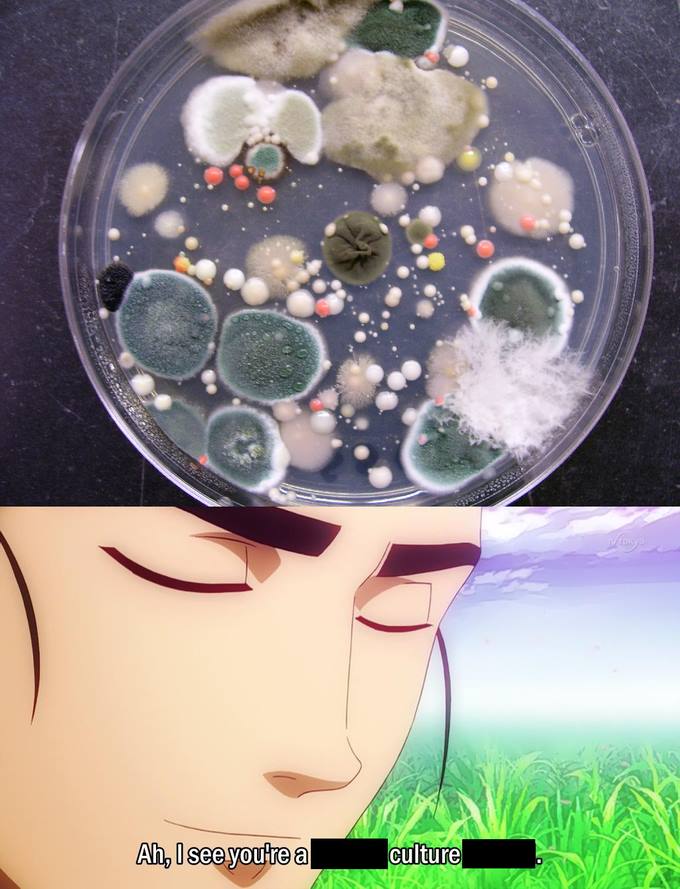
featured

toddbonzales (63)
322 followers170 posts11 following0 HP
Blacklisted UsersMuted UsersFollowed BlacklistsFollowed Muted Lists
Blacklisted UsersMuted UsersFollowed BlacklistsFollowed Muted Lists
Joined February 2018 Active 7 years ago